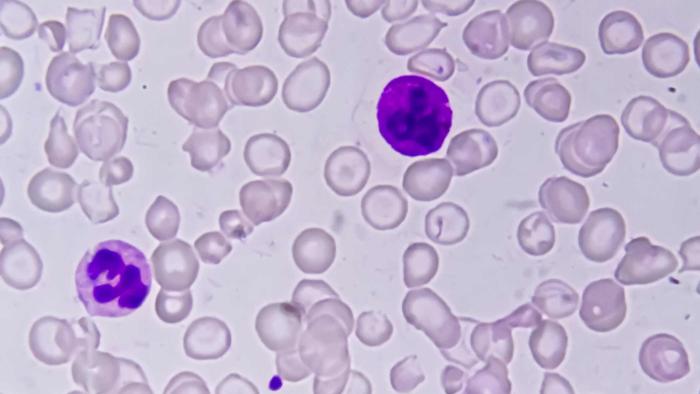
Anemia

Listado de tags
El SMC EN


What you need when science makes the news
All researchers who contribute to the Science Media Centre Spain as expert sources are listed here.
Here you can locate the institutions in the SMC Spain directory and their press contacts. If you would like to make any changes, please contact us.
You will have access to our embargoed content so that you can work on your information in good time. Don’t miss anything!

You can participate as an expert source on the topics we cover.

We are part of the international SMC network, which has six members spread across different countries. Its origin lies in the creation of the UK SMC in 2002. If you want to create a Science Media Centre in your country, check the requirements on the network's website.

Find reactions, analysis or resources including keywords.
We offer you different formats with more or less depth and immediacy depending on current events. They have a Creative Commons licence and you can use them quoting SMC Spain as the source.
If you are part of any of these three groups, SMC Spain adapts to your needs.
SMC Spain has a scholarship programme for students who want to train as science, technology, health and environmental journalists.
On this occasion, we've asked journalists and researchers: How does the work of SMC Spain help you? Here are their video responses.
The SMC Spain aims to contribute to the accurate portrayal of science in the media, with context, expert sources, and the best available evidence. Only in this way can we improve the quality of public discussion on the many current issues related to science.
This voluntary team of independent experts provides specialized knowledge and advice to the team of the SMC Spain.
Useful guides on science communication and key aspects of different branches of science.
Pagination
- Previous page
- Page 36